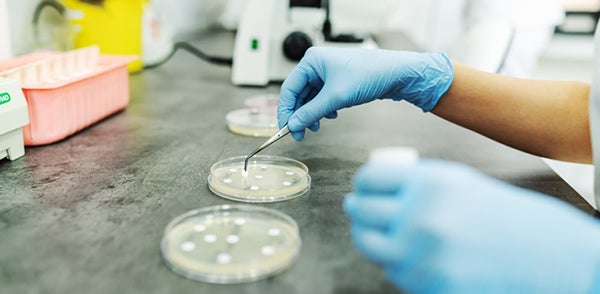

Follow the Milk
What happens to the milk once it is donated?
Our Process:
STEP 1: Donation
Moms donate their frozen milk.

STEP 2: Lab Testing
A sample from each donation is sent to the lab for testing.
STEP 3: Pooling
Thawed milk from multiple donors is pooled together.

STEP 4: Homogenization
Milk is homogenized/mixed several times to ensure fat is uniformly distributed throughout the milk.

STEP 5: Pouring
Milk is poured into tamper evident, BPA-free bottles.

STEP 6: Pasteurizing
Bottles are heated to 62.5°C for 30 minutes to kill viruses and bacteria.

STEP 7: More Lab Testing
Another sample of pasteurized milk is sent to the lab for testing. This ensures the absence of potentially harmful bacteria.

STEP 8: Freezing
Pasteurized milk is kept at -20°C until it is dispensed to hospitals and outpatients for use.

For questions about milk processing, email us at milklab@wakemed.org.